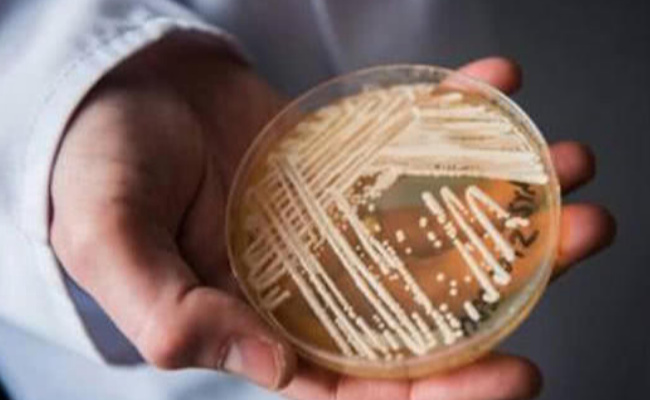

致命真菌在美国蔓延 耳念珠菌究竟从何而来?
致命真菌在美国蔓延的原因可能与环境和气候变化、人类活动、医疗设施和人类行为等多个因素有关,随着时间的推移,致命真菌在美国不断蔓延,成为一个不容忽视的问题。其中,耳念珠菌是最近备受关注的一种致命真菌,它已经在美国多个州被发现。耳念珠菌是一种真菌,主要感染人类的耳朵和呼吸道。它最初是在日本被发现的,但在过去几年中,它已经在全球范围内蔓延。在美国,耳念珠菌已经在多个州被发现,包括伊利诺伊州、纽约州、新泽西州、加利福尼亚州等等。

耳念珠菌在美国蔓延,一些专家认为,这可能与过度使用抗生素和抗真菌药物有关,这些药物不仅会杀死有害的细菌和真菌,也会破坏有益的微生物群落,导致人体免疫力下降,从而让耳念珠菌有机可乘。
此外,耳念珠菌也可能通过医疗设备和医院环境传播,由于它是一种耐药性强的真菌,传播速度非常快。如果医院没有采取适当的措施,就很容易在医院内传播。一些专家也认为气候变化可能是耳念珠菌蔓延的一个因素。随着气候变暖,一些真菌的生长速度也会加快,从而使得它们更容易在人体内生长和繁殖。

不管是什么原因导致了耳念珠菌在美国的蔓延,这都是一个非常严峻的问题。因为耳念珠菌是一种非常致命的真菌,它可以引起严重的感染,特别是对于那些免疫系统较弱的人来说,非常危险。目前,医学界正在积极探索对付耳念珠菌的方法,一些新的抗真菌药物已经被研发出来,但是这些药物的使用范围非常有限,因为它们可能会对人体产生副作用。另外,一些专家也建议采取一些预防措施,如加强个人卫生和医院环境的清洁等等。
标签:
203
这个冬天疫情为何此起彼伏(为什么病毒在冬天更厉害) #1传44!大连疫情现超级传播现象# 今年由于拉尼娜现象的影响,天气比往年更加寒冷,冬季流感的爆发使得尚未控制住的新冠疫...
161
预防食道癌从生活的点滴做起 预防食道癌 现如今谈癌色变,人们面对癌症需要多多预防。一旦确诊为癌症,需要积极配合医生。毕竟人类健康受到影响,将会影响正常工作和生活。而...
176
银行卡突然多了钱会被要回去吗 卡里莫名其妙多了钱要还吗? 虽然我们自己的银行卡里面突然多了很多钱,但是这笔钱本来就不属于我们最终是需要归还的,建议小伙伴们在生活中发现...
288
压轴是最后一个还是倒数第二个(压轴代表什么意思) 我们生活中所理解的压轴,究竟是什么意思呢?是不是理所当然地认为压轴是在最后出场的节目呢? 压轴是最后一个还是倒数第...
172
手机数据线老爱断怎么办 手机数据线老爱断该怎么处理 手机可以频繁的使用,但是数据线经常断了,这都是比较正常的情况。举个简单的例子,平时我们使用iPhone手机,一部手机可以...
103
甲鱼怎么养在家比较好(小甲鱼如何进行人工孵化呢) 模拟自然方式养甲鱼,从卵中孵化出的幼苗到养成商品甲鱼,一般需3~5年。采取养殖新技术,从孵化到养成商品甲鱼,只需1年多...
112
花蛤放了一夜吐舌头能吃吗 花蛤泡了一晚全部吐舌头还能吃吗 花蛤放了一夜,吐舌头不能再吃,花蛤属于海鲜食品中的一种,目前烹饪花蛤的方式有多种,人们可以根据自己的喜好选...
73
2023年除夕要给女朋友发红包吗 2023年跨年该不该给女朋友发红包 现如今是互联网时代,人们会利用互联网进行交流沟通传递感情,而2023年除夕夜想要给女朋友发红包是非常好的,毕竟...
196
紫薯怎么吃减肥效果最好 紫薯怎么吃减肥 我们想要利用紫薯减肥产生最好的效果,建议直接将紫薯蒸着吃,一般在蒸紫薯时可以利用蒸汽或者是将紫薯煮沸腾,以后人们吃了这类紫薯...
262
芝麻信用极好(芝麻信用极好和优秀哪个等级更高) 芝麻信用极好 IT之家8月12日消息 随着社会的不断发展,信用对一个人的重要程度也越来越高。而芝麻支付宝也开通区别了芝麻信用分的...
166
衣物多久洗一次好 衣服多久要清洗一次最好 在生活中我们总是遇到这样或者是那样的问题,可能有些问题给我们造成了困扰,但是我们要是尝试使用一些小妙招的话,通常可以有效的...
72
椰子油的生活小妙用 椰子油的生活小妙用 在生活中我们所说的椰子油其实就是一种植物的胚乳经过榨汁提炼之后所形成的一种油,通常情况下椰子油是为白色的,而经过特殊处理之后...
133
虾吃什么东西怎么养(如何喂养) 有些人养虾多年却不会正确的喂虾,你真的会喂虾吗?是看别人怎么去喂虾你跟着学喂虾,还是根据自己虾塘的大小,水温,水质以及养殖模式来具体...
218
五金在领证前买还是领证后买 买五金和领证的顺序是什么 面对结婚五金到底是在领证前买还是在领证后买,个人觉得根据自己的情况进行选择,有些小伙伴直接在领证前购买,也有部...
146
我国沙尘暴多发生在哪些地区 我国沙尘暴多发于西北地区和华北地区。 在西北地区,沙尘暴主要集中在塔里木盆地周边地区、内蒙古阿拉善高原以及河套平原等地。 在华北地区,沙尘...
121
灵异故事大全真实故事(真实的鬼故事灵异事件) 有一件亲身经历的怪事。 那是十一年前父亲因病去世,心中悲、痛难以言表。 按照我们当地习俗,人去世后的第一个七天称为头七,这...
112
卡路里低的零食(热量最低的零食) 减脂期也可以吃零食!只要你会选,低卡零食解馋还能瘦!下面8条减脂零食挑选标准分享给大家: 学会看食品配料表。配料表一般排在第一位的成分...
210
巨蟹座女的致命弱点(巨蟹座女生的性格特点及软肋) 巨蟹女其实是一个低调的星座,她们平时在小事上有点迷糊,但是在大事上很聪慧有主见。她们性格善良敏感,有强烈的同情心与...
214
季节变更怎样预防传染病 夏季传染病高发,如何预防? 每当季节变换之后,气候也会发生改变,病毒在这个时候就会趁虚而入,由于成年人抵抗力特别强,一般在季节变换时不会生病...
179
抖音找塞班是什么梗都以为塞班是狗结果令人万万没想到 今年对于全国人民来说,这是很特别的一年,因为疫情的原因,使得很多人不得不宅在家里,所以有很多人在刷抖音或者是看其...